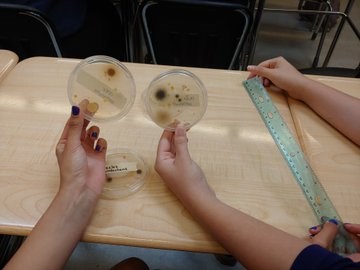

Studying mathematics in the summer is time well spent for many students across North Vancouver.
"Having the course condensed makes it easier. I don't forget as much because I'm taking the class every day," said Will, a Sutherland Secondary student who signed up for Pre-Calculus 11.


Pre-Calculus 11 with teacher Stephanie Maxwell
The diverse suite of course offerings at North Vancouver School District's Summer Learning attracted 1,200 students to Carson Graham Secondary in July. Summer Learning programs support English language learners, students transitioning to high school, those in Grade 8 and 9 looking to enhance core math, literacy and language skills, and those who aim to earn advanced credit towards graduation. The elementary program runs later this summer at Westview Elementary.
Just like during the regular school year in classrooms across the school district, students at Summer Learning make discoveries as they explore new ideas and master new skills. In the school's science labs, menacing bacteria was grown and examined closely, young biologists dissected pigs, and chemists in Mr. Bulger's class explored polarity while making soap.
Ali Lansing's Life Sciences 11 found bacteria on places like keyboards and door handles. They were exploring antiseptics, antibiotics and disinfectants.
Expository essays took shape in Mr. Murphy's English Studies 12 class as students explored how storytelling deepens understanding of ideas and the world.
"I feel I've learned the skill set for after high school for writing essays – to put my ideas to paper with clear thinking and clear writing," said Grade 12 student, Earlene.

Physical and Health Education 10 was a new addition to the Summer Learning lineup this year. Students enjoyed this alternative way to earn credits – from climbing Quarry Rock, swimming at Whyte Lake and rowing in Deep Cove, to planning a healthy personal workout routine. This course encouraged and taught students how to live healthy and active lives.

On July 23, the culmination of deep learning that transpired during this year's Summer Learning program for secondary students was honoured in a unique way. The annual school-wide Celebration of Learning had students, one by one, walk into the Carson Graham cafeteria where a giant concept map made from paper cards was laid out. The cards, coloured with words and images by each learner, expanded on a big idea, such as open-mindedness or confidence. Using cards to record their ideas, students connected their learning from across the curriculum to transdisciplinary concepts like equality, structure and communication.
An English 12 student explored the idea of communication and suggested human connection is the key to personal and career success: "One key to good communication in relationships is listening to what is being said and what is not," the student wrote on her learning card.
Summer Learning principal Kathleen Barter stands with the concept map

Students poured over the map and, using coloured tape, strung connections from their card to other cards in the concept web. Links were made by students both with their course's materials and concepts, as well as with the concepts and big ideas in other classes. Students in Grades 8 through 12 connected their ideas to the ideas of others, thus coming together as a community of learners, thinkers and social creatures.
Summer Learning Principal Kathleen Barter said the concept map provided students with a framework for meaningful reflection around their course and their experience at Summer Learning.
"Students were surprised by the number of connections made between each card," said Barter.
From the Celebration of Learning, another lesson emerged.
"Courtney Brown's class did some data analysis on the concept map to look at the percentage of students who connected to each concept," explained Barter.
Mr. Bjornson's Exploration of Social Studies students returned to the completed map and, used linking verbs, justified what they thought of the relationships between ideas.
After visiting the concept map, the next day one student wrote: "It's amazing to see how many people think differently about the same thing, yet our world is still able to run smoothly."
Over the past number of years, not only has there been a significant increase in student enrolment in summer programs, but there has also been an increased demand in teacher's applying to teach in Summer Learning. Many teachers comment on the collaborative nature of practice during the summer and the ability to try new things prior to the school year.